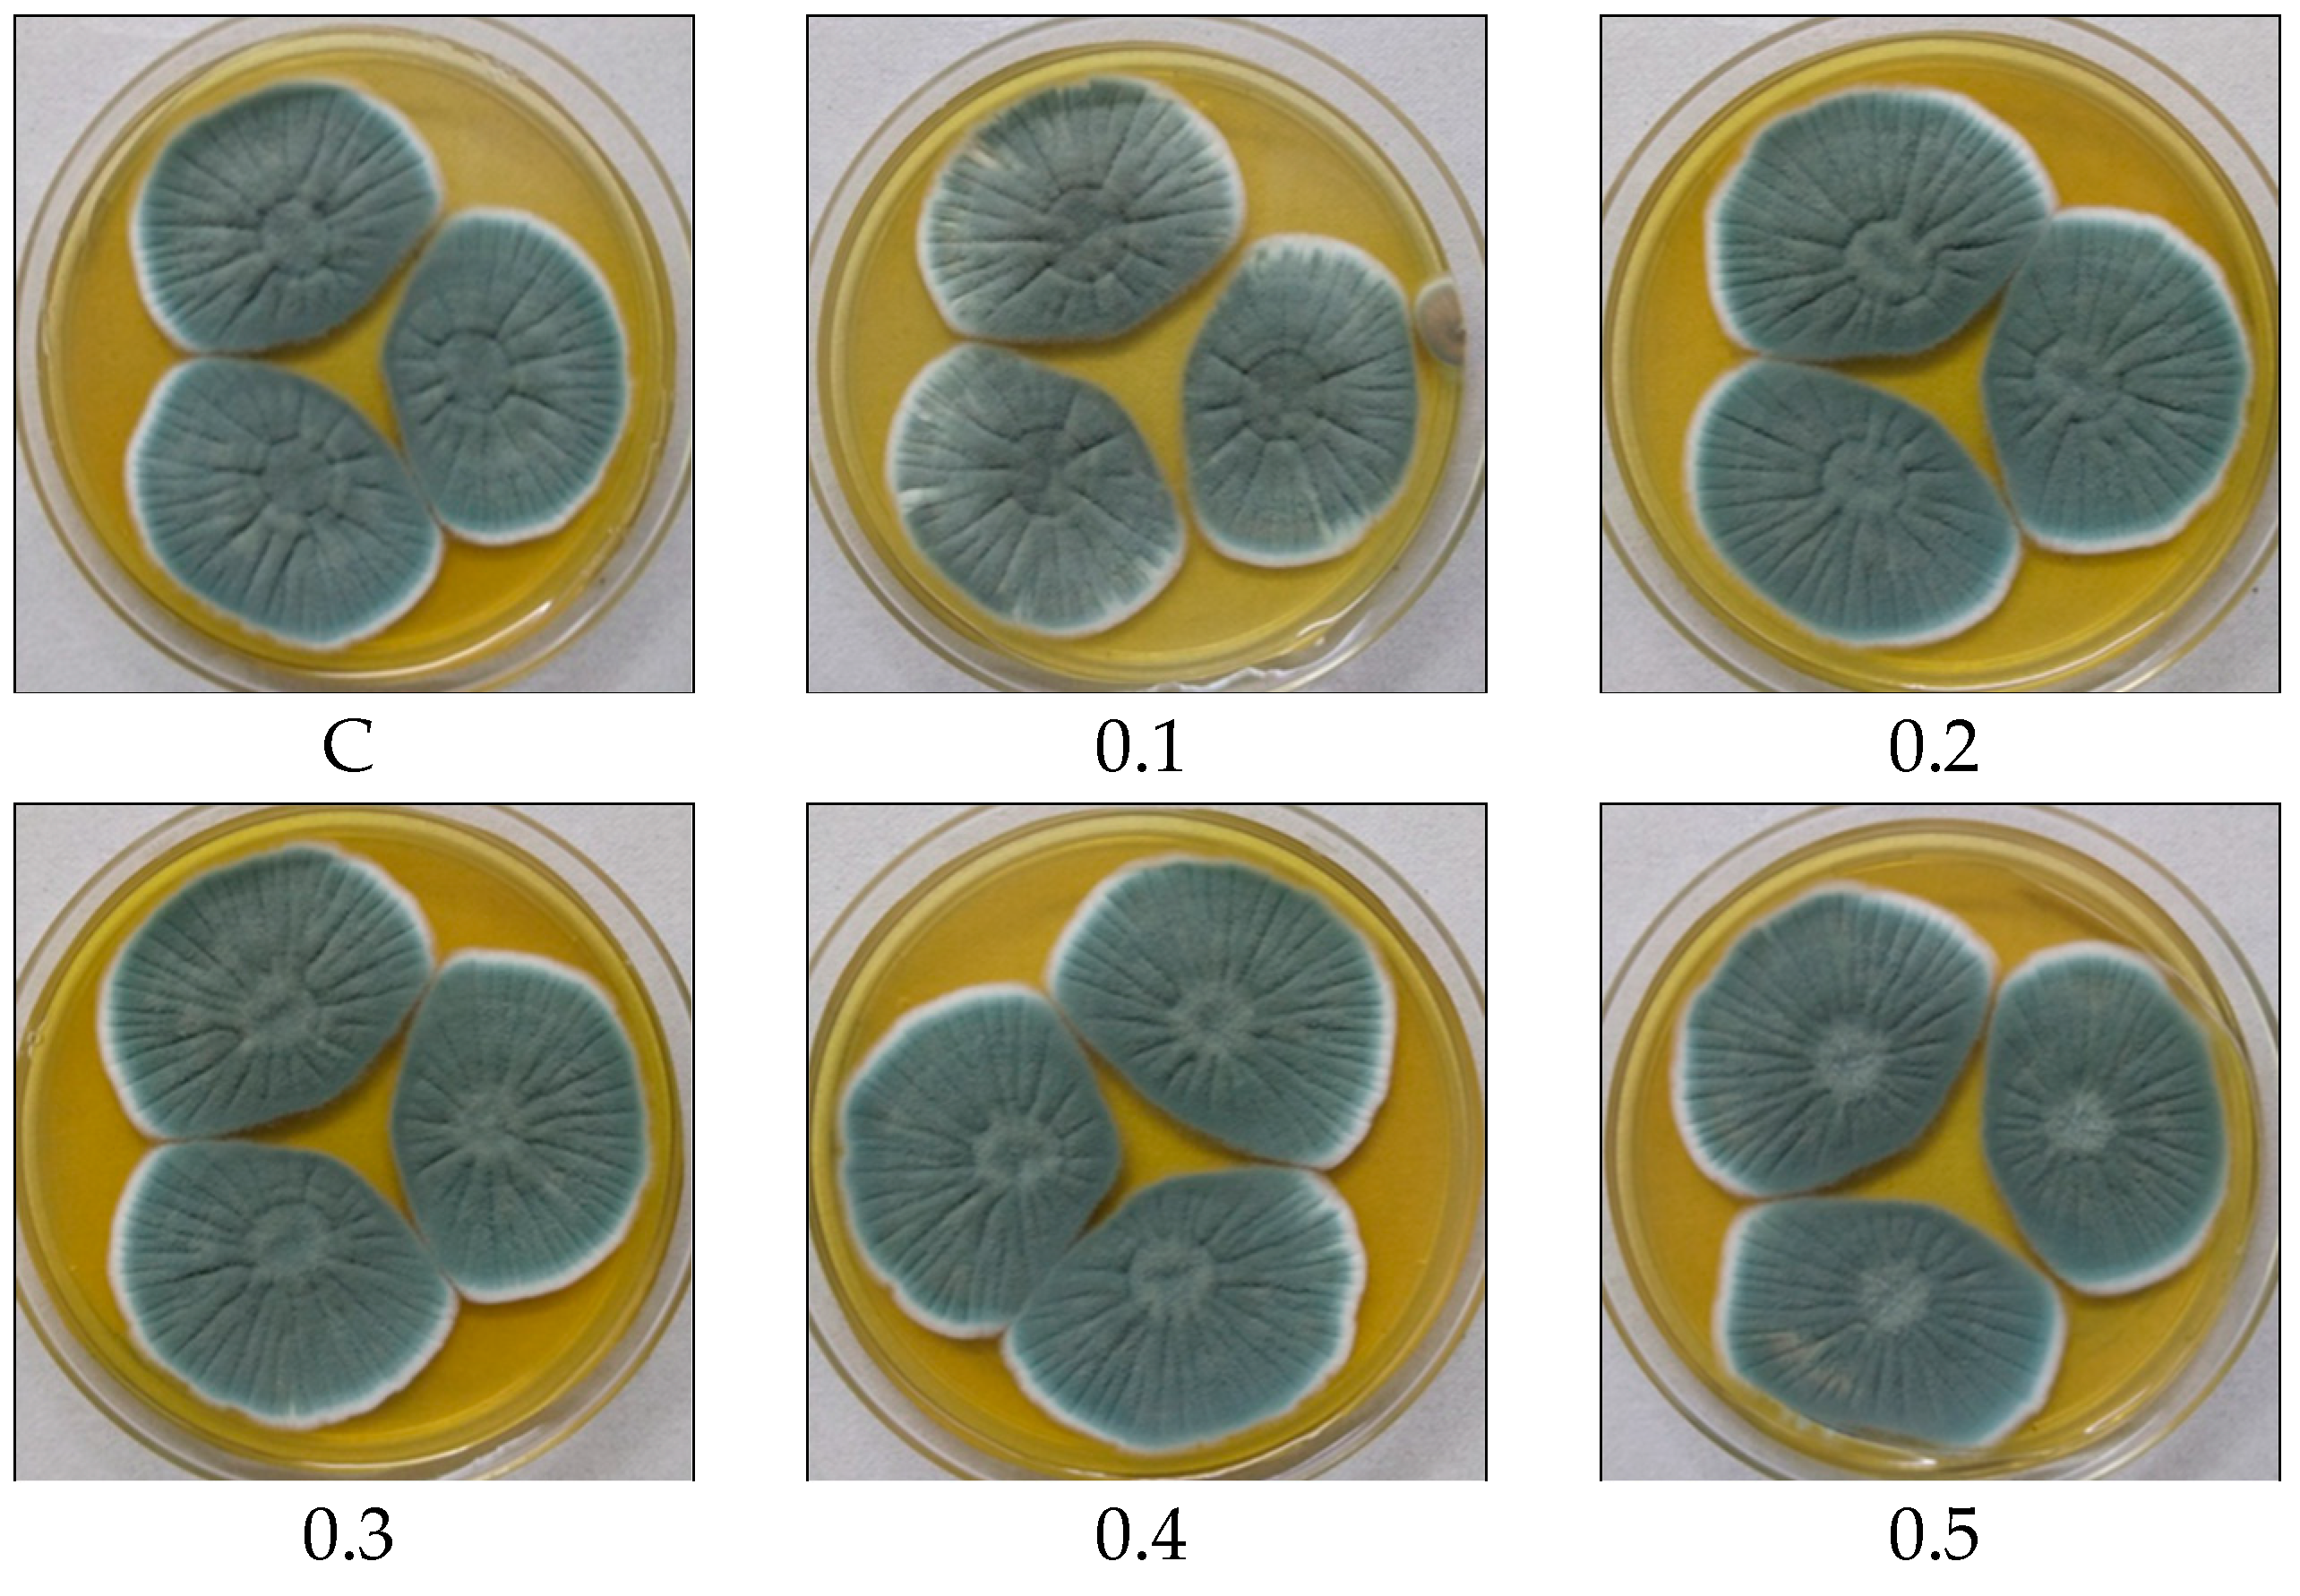
Microorganisms 11 01132 g005a

Isolation and Molecular Characterization of Indigenous Penicillium chrysogenum/rubens Strain Portfolio for Penicillin V Production
Abstract
1. Introduction
2. Materials and Methods
2.1. Chemicals and Reagents
2.2. Isolation and Morphological Characterization of Fungi
2.3. Molecular Identification of Fungi
2.3.1. ITS Region Amplification
2.3.2. BenA Gene Amplification
2.4. ITS and BenA Gene Sequence Analysis
2.5. Metabolic Profiling Using LC-HRMS
2.6. Biosynthesis of PenV Using Submerged Fermentation
2.7. Optimization of Fermentation Parameters for PenV Production
2.8. Downstream Processing (DSP) of PenV
2.9. Antibiotic Sensitivity Assay for PenV Production
2.10. Development of HPLC Method for Detection of PenV, POA, and 6-APA
3. Results
3.1. Isolation and Morphological Identification of Fungal Species
3.2. Molecular Identification by ITS Regions
3.3. Molecular Identification by BenA Gene
3.4. Metabolic Profiling by LC–HRMS
3.5. PenV Production
3.6. Optimization Fermentation Parameters
3.7. DSP and Recovery of PenV
3.8. Antibiotic Plate Assay
3.9. Development of an HPLC Method for the Detection of PenV, POA, and 6-APA
4. Discussion
5. Conclusions
Supplementary Materials
Author Contributions
Funding
Institutional Review Board Statement
Informed Consent Statement
Data Availability Statement
Acknowledgments
Conflicts of Interest
References
- Wu, B.; Hussain, M.; Zhang, W.; Stadler, M.; Liu, X.; Xiang, M. Current insights into fungal species diversity and perspective on naming the environmental DNA sequences of fungi. Mycology 2019, 10, 127–140. [Google Scholar] [CrossRef] [PubMed]
- Navale, V.; Vamkudoth, K.R.; Ajmera, S.; Dhuri, V. Aspergillus derived mycotoxins in food and the environment: Prevalence, detection, and toxicity. Toxicol. Rep. 2021, 8, 1008–1030. [Google Scholar] [CrossRef] [PubMed]
- Wang, Y.P.; Chen, Y.C.; Chang, W.; Lin, C.L. Mutant Strain of Penicillium citrinum and Use Thereof for Preparation of Compactin. U.S. Patent 6323021, 27 November 2001. [Google Scholar]
- Houbraken, J.; Frisvad, J.C.; Samson, R.A. Fleming’s penicillin producing strain is not Penicillium chrysogenum but P. rubens. IMA Fungus 2011, 2, 87–95. [Google Scholar] [CrossRef] [PubMed]
- Refai, M.; El-Yazid, H.A.; Tawakkol, W. Monograph on the Genus Penicillium: A Guide for Historical, Classification, and Identification of Penicillin, their Industrial Applications and Detrimental Effects; Cairo University: Giza, Egypt, 2015. [Google Scholar]
- Shaaban, M.; Sohsah, G.E.; Magdy El-Metwally, M.; Elfedawy, M.G.; Abdel-Mogib, M. Bioactive compounds produced by strain of Penicillium sp. Int. J. Eng. Appl. 2016, 5, 7560. [Google Scholar] [CrossRef]
- Leitão, A.L.; Enguita, F.J. Gibberellins in Penicillium strains: Challenges for endophyte-plant host interactions under salinity stress. Microbiol. Res. 2016, 183, 8–18. [Google Scholar] [CrossRef]
- Boruta, T.; Przerywacz, P.; Ryngajllo, M.; Bizukojc, M. Bioprocess-related, morphological and bioinformatic perspectives on the biosynthesis of secondary metabolites produced by Penicillium solitum. Process Biochem. 2018, 68, 12–21. [Google Scholar] [CrossRef]
- Bilal, S.; Shahzad, R.; Khan, A.L.; Al-Harrasi, A.; Kim, C.K.; Lee, I.J. Phytohormones enabled endophytic Penicillium funiculosum LHL06 protects Glycine max L. from synergistic toxicity of heavy metals by hormonal and stress-responsive proteins modulation. J. Hazard. Mater. 2019, 379, 120824. [Google Scholar] [CrossRef]
- Kozlovsky, A.G.; Kochkina, G.A.; Zhelifonova, V.P.; Antipova, T.V.; Ivanushkina, N.E.; Ozerskaya, S.M. Secondary metabolites of the genus Penicillium from undisturbed and anthropogenically altered Antarctic habitats. Folia. Microbiol. 2020, 65, 95–102. [Google Scholar] [CrossRef]
- Visagie, C.M.; Houbraken, J.; Frisvad, J.C.; Hong, S.B.; Klaassen, C.H.; Perrone, G.; Seifert, K.A.; Varga, J.; Yaguchi, T.; Samson, R.A. Identification and nomenclature of the genus Penicillium. Stud. Mycol. 2014, 78, 343–371. [Google Scholar] [CrossRef]
- Frisvad, J.C.; Samson, R.A. Polyphasic taxonomy of Penicillium subgenus Penicillium: A guide to identification of food and air-borne terverticillate Penicillia and their mycotoxins. Stud. Mycol. 2004, 49, 1–173. [Google Scholar]
- Sawant, A.M.; Vankudoth, R.; Navale, V.; Kumabat, R.; Kumari, P.; Shantakumari, B.; Vamkudoth, R.V. Morphological and molecular characterization of Penicillium rubens sp. nov isolated from poultry feed. Indian Phytopathol. 2019, 72, 461–478. [Google Scholar] [CrossRef]
- White, T.J.; Bruns, T.; Lee, S.; Taylor, J. Amplification of direct sequencing of fungal ribosomal RNA genes for phylogenetics. In PCR Protocols: A Guide to Method and Applications; Innis, D., Gelfand, H., Sninsky, J.J., Eds.; Academic Press Inc.: New York, NY, USA, 1990. [Google Scholar]
- Schoch, C.L.; Seifert, K.A.; Huhndorf, S.; Robert, V.; Spouge, J.L.; Levesque, C.A.; Chen, W. Nuclear ribosomal internal transcribed spacer (ITS) region as a universal DNA barcode marker for Fungi. Proc. Natl. Acad. Sci. USA 2012, 109, 6241–6246. [Google Scholar] [CrossRef] [PubMed]
- Morán-Díaz, J.R.; Jiménez-Vázquez, H.A.; Gómez-Pliego, R.; Arellano-Mendoza, M.G.; Quintana-Zavala, D.; Guevara-Salazar, J.A. Correlation study of antibacterial activity and spectrum of Penicillins through a structure-activity relationship analysis. Med. Chem. Res. 2019, 28, 1529–1546. [Google Scholar] [CrossRef]
- Chandel, A.K.; Rao, L.V.; Narasu, M.L.; Singh, O.V. The realm of penicillin acylase in beta-lactam antibiotics. Enzyme Microb. Technol. 2008, 42, 199–207. [Google Scholar] [CrossRef]
- Nandi, A.; Pan, S.; Potumarthi, R.; Danquah, M.K.; Sarethy, I.P. A proposal for six sigma integration for large-scale production of penicillin G and subsequent conversion to 6-APA. J. Anal. Methods Chem. 2014, 2014, 413616. [Google Scholar] [CrossRef]
- Sawant, A.M.; Sunder, A.V.; Vamkudoth, K.R.; Ramasamy, S.; Pundle, A. Process development for 6-Aminopenicillanic acid production using lentikats-encapsulated Escherichia coli Cells expressing penicillin V acylase. ACS Omega 2020, 5, 28972–28976. [Google Scholar] [CrossRef]
- Ventola, C.L. The antibiotic resistance crisis: Part 1: Causes and threats. Pharm. Ther. 2015, 40, 277–283. [Google Scholar]
- Glass, N.L.; Donaldson, G.C. Development of primer sets designed for use with the PCR to amplify conserved genes from filamentous ascomycetes. Appl. Environ. Microbiol. 1995, 61, 1323–1330. [Google Scholar] [CrossRef]
- Smedsgaard, J. Micro-scale extraction procedure for standardized screening of fungal metabolite production in cultures. J. Chromatogr. A 1997, 760, 264–270. [Google Scholar] [CrossRef]
- Yakhkind, M.I.; Tarantseva, K.R.; Marynova, M.A.; Storozhenko, P.A.; Rasulov, M.M. Recovery of biosynthetic penicillins. In Advances in Medicine and Biology; Nova Science Publishers: Hauppauge, NY, USA, 2014; Volume 79. [Google Scholar]
- Raper, K.B.; Thom, C. A Manual of the Penicillia; Williams & Wilkins: Baltimore, ML, USA, 1949; pp. 368–370. [Google Scholar]
- Dulaney, E.L. Penicillin production by the Aspergillus nidulans group. Mycologia 1947, 39, 582–586. [Google Scholar] [CrossRef]
- Rao, V.K.; Shilpa, P.; Girisham, S.; Reddy, S.M. Incidence of mycotoxigenic penicillia in feeds of Andhra Pradesh, India. Int. J. Biotechnol. Mol. Biol. Res. 2011, 2, 46–50. [Google Scholar]
- Rao, V.K.; Girisham, S.; Reddy, S.M. Prevalence of toxigenic Penicillium species associated with poultry house in Telangana, India. Arch. Environ. Occup. Health 2016, 71, 353–361. [Google Scholar]
- Dayalan, S.A.; Darwin, P.; Prakash, S. Comparative study on production, purification of penicillin by Penicillium chrysogenum isolated from soil and citrus samples. Asian Pac. J. Trop. Biomed. 2011, 1, 15–19. [Google Scholar] [CrossRef] [PubMed]
- Yin, G.; Zhang, Y.; Pennerman, K.K.; Wu, G.; Hua, S.S.T.; Yu, J.; Jurick, W.M.; Guo, A.; Bennett, J.W. Characterization of blue mold penicillium species isolated from stored fruits using multiple highly conserved loci. J. Fungi 2017, 3, 12. [Google Scholar] [CrossRef] [PubMed]
- Barbosa, R.N.; Bezerra, J.D.P.; Souza-Motta, C.M.; Frisvad, J.C.; Samson, R.A.; Oliveira, N.T.; Houbraken, J. New Penicillium and Talaromyces species from honey, pollen and nests of stingless bees. Antonie Van Leeuwenhoek 2018, 111, 1883–1912. [Google Scholar] [CrossRef] [PubMed]
- Houbraken, J.; Samson, R.A. Phylogeny of Penicillium and the segregation of Trichocomaceae into three families. Stud. Mycol. 2011, 70, 1–51. [Google Scholar] [CrossRef]
- Peterson, S.W. Phylogenetic analysis of Penicillium species based on ITS and LSU-rDNA nucleotide sequences. In Integration of Modern Taxonomic Methods for Penicillium and Aspergillus Classification; Samson, R.A., Pitt, J.I., Eds.; Harwood Academic Publishers: Amsterdam, The Netherlands, 2000; pp. 163–178. [Google Scholar]
- Abastabar, M.; Mirhendi, H.; Hedayati, M.T.; Shokohi, T.; Rezaei-Matehkolaei, A.; Mohammadi, R.; Badali, H.; Moazeni, M.; Haghani, I.; Ghojoghi, A.; et al. Genetic and morphological diversity of the genus Penicillium from Mazandaran and Tehran Provinces, Iran. Jundishapur J. Microbiol. 2016, 9, e28280. [Google Scholar] [CrossRef] [PubMed]
- Villarino, M.; De Cal, A.; Melgarejo, P.; Larena, I.; Espeso, E.A. The development of genetic and molecular markers to register and commercialize Penicillium rubens (formerly Penicillium oxalicum) strain 212 as a biocontrol agent. Microb. Biotechnol. 2016, 9, 89–99. [Google Scholar] [CrossRef]
- Cruickshank, R.H.; Pitt, J.I. The zymogram technique: Isoenzyme patterns as an aid in Penicillium classification. Microbiol. Sci. 1987, 4, 14–17. [Google Scholar]
- Houbraken, J.; Frisvad, J.C.; Seifert, K.A.; Overy, D.P.; Tuthill, D.M.; Valdez, J.G.; Samson, R.A. New penicillin-producing Penicillium species and an overview of section Chrysogena. Persoonia 2012, 29, 78–100. [Google Scholar] [CrossRef]
- de la Campa, R.; Seifert, K.; Miller, J.D. Toxins from strains of Penicillium chrysogenum isolated from buildings and other sources. Mycopathologia 2007, 163, 161–168. [Google Scholar] [CrossRef] [PubMed]
- Bugni, T.S.; Bernan, V.S.; Greenstein, M.; Janso, J.E.; Maiese, W.M.; Mayne, C.L.; Ireland, C.M. Brocaenols A-C: Novel polyketides from a marine derived Penicillium brocae. J. Org. Chem. 2003, 68, 2014–2017. [Google Scholar] [CrossRef] [PubMed]
- Peterson, S.W.; Pérez, J.; Vega, F.E.; Infante, F. Penicillium brocae, a new species associated with the coffee berry borer in Chiapas, Mexico. Mycologia 2003, 95, 141–147. [Google Scholar] [CrossRef]
- Wang, L.; Zhang, X.; Zhang, K.; Zhang, X.; Zhu, T.; Che, Q.; Zhang, G.; Li, D. Overexpression of global regulator Pbrlaea leads to the discovery of new polyketide in fungus Penicillium brocae HDN-12-143. Front. Chem. 2020, 8, 270. [Google Scholar] [CrossRef] [PubMed]
- Meng, L.H.; Li, X.M.; Lv, C.T.; Huang, C.G.; Wang, B.G. Brocazines A-F, cytotoxic bisthiodiketopiperazine derivatives from Penicillium brocae ma-231, an endophytic fungus derived from the marine mangrove plant Avicennia marina. J. Nat. Prod. 2014, 77, 1921–1927. [Google Scholar] [CrossRef] [PubMed]
- Meng, L.H.; Zhang, P.; Li, X.M.; Wang, B.G. Penicibrocazines A–E, five new sulfide diketopiperazines from the marine-derived endophytic fungus Penicillium brocae. Mar. Drugs 2015, 13, 276–287. [Google Scholar] [CrossRef]
- Meng, L.H.; Wang, C.Y.; Mándi, A.; Li, X.M.; Hu, X.Y.; Kassack, M.U.; Kurtán, T.; Wang, B.G. Three diketopiperazine alkaloids with spirocyclic skeletons and one bisthiodiketopiperazine derivative from the mangrove-derived endophytic fungus Penicillium brocae MA-231. Org. Lett. 2016, 18, 5304–5307. [Google Scholar] [CrossRef]
- Chu, Y.C.; Chang, C.H.; Liao, H.R.; Cheng, M.J.; Wu, M.D.; Fu, S.L.; Chen, J.J. Rare chromone derivatives from the marine-derived Penicillium citrinum with anticancer and anti-inflammatory activities. Mar. Drugs 2021, 19, 25. [Google Scholar] [CrossRef]
- Chu, Y.C.; Chang, C.H.; Liao, H.R.; Fu, S.L.; Chen, J.J. Anti-cancer and anti-inflammatory activities of three new chromone derivatives from the marine-derived Penicillium citrinum. Mar. Drugs 2021, 19, 408. [Google Scholar] [CrossRef]
- da Costa, S.G.; Pereira, O.L.; Teixeira-Ferreira, A.; Valente, R.H.; de Rezende, S.T.; Guimarães, V.M.; Genta, F.A. Penicillium citrinum UFV1 β-glucosidases: Purification, characterization, and application for biomass saccharification. Biotechnol. Biofuels 2018, 11, 226. [Google Scholar] [CrossRef]
- Salendra, L.; Lin, X.; Chen, W.; Pang, X.; Luo, X.; Long, J.; Liao, S.; Wang, J.; Zhou, X.; Liu, Y.; et al. Cytotoxicity of polyketides and steroids isolated from the sponge-associated fungus Penicillium citrinum SCSIO 41017. Nat. Prod. Res. 2021, 35, 900–908. [Google Scholar] [CrossRef]
- Thissera, B.; Sayed, A.M.; Hassan, M.; Abdelwahab, S.F.; Amaeze, N.; Semler, V.T.; Alenezi, F.N.; Yaseen, M.; Alhadrami, H.A.; Belbahri, L.; et al. Bioguided isolation of cyclopenin analogues as potential SARS-CoV-2 Mpro inhibitors from Penicillium citrinum TDPEF34. Biomolecules 2021, 11, 1366. [Google Scholar] [CrossRef] [PubMed]
- Maketon, M.; Amnuaykanjanasin, A.; Kaysorngup, A. A rapid knockdown effect of Penicillium citrinum for control of the mosquito Culex quinquefasciatus in Thailand. World J. Microbiol. Biotechnol. 2014, 30, 727–736. [Google Scholar] [CrossRef]
- Khan, S.A.; Hamayun, M.; Yoon, H.; Kim, H.Y.; Suh, S.J.; Hwang, S.K.; Kim, J.M.; Lee, I.J.; Choo, Y.S.; Yoon, U.H.; et al. Plant growth promotion and Penicillium citrinum. BMC Microbiol. 2008, 8, 231. [Google Scholar] [CrossRef] [PubMed]
- Jin, X.; Song, J.; Ma, J.; Liu, G.Q. Thermostable β-xylosidase from Aspergillus fumigatus: Purification, characterization and potential application in lignocellulose bioethanol production. Renew. Energy 2020, 155, 1425–1431. [Google Scholar] [CrossRef]
- Liu, D.; Zhang, R.; Yang, X.; Wu, H.; Dabing, X.; Tang, Z.; Shen, Q. Thermostable cellulase production of Aspergillus fumigatus Z5 under solid-state fermentation and its application in degradation of agricultural wastes. Int. Biodeterior. Biodegrad. 2011, 65, 717–725. [Google Scholar] [CrossRef]
- Singh, S.; Mangla, J.; Singh, S. Evaluation of Aspergillus fumigatus NTCC1222 as a source of enzymes for detergent industry. Resour. Environ. Sustain. 2021, 5, 100030. [Google Scholar] [CrossRef]
- Okonji, R.E.; Itakorode, B.O.; Ovumedia, J.O.; Adedeji, O.S. Purification and biochemical characterization of pectinase produced by Aspergillus fumigatus isolated from soil of decomposing plant materials. J. Appl. Biol. Biotechnol. 2019, 7, 1–8. [Google Scholar]
- Suresh, N.; Das, A. Purification and characterization of phosphatases from Aspergillus fumigatus for applications in industrial uses. Rasayan. J. Chem. 2014, 7, 118–128. [Google Scholar]
- Alwakeel, S.S.; Ameen, F.; Al Gwaiz, H.; Sonbol, H.; Alghamdi, S.; Moharram, A.M.; Al-Bedak, O.A. Keratinases produced by Aspergillus stelliformis, Aspergillus sydowii, and Fusarium brachygibbosum isolated from human hair: Yield and activity. J. Fungi 2021, 7, 471. [Google Scholar] [CrossRef]
- Amin, M.; Liang, X.; Ma, X.; Dong, J.D.; Qi, S.H. New pyrone and cyclopentenone derivatives from marine-derived fungus Aspergillus sydowii SCSIO 00305. Nat. Prod. Res. 2021, 35, 318–326. [Google Scholar] [CrossRef] [PubMed]
- Niu, S.; Chen, Z.; Pei, S.; Shao, Z.; Zhang, G.; Hong, B. Acremolin D, a new acremolin alkaloid from the deep-sea sediment derived Aspergillus sydowii fungus. Nat. Prod. Res. 2022, 36, 4936–4942. [Google Scholar] [CrossRef] [PubMed]
- Li, W.T.; Luo, D.; Huang, J.N.; Wang, L.L.; Zhang, F.G.; Xi, T.; Liao, J.M.; Lu, Y.Y. Antibacterial constituents from Antarctic fungus, Aspergillus sydowii SP-1. Nat. Prod. Res. 2018, 32, 662–667. [Google Scholar] [CrossRef] [PubMed]
- Eakjamnong, W.; Keawsalong, N.; Dethoup, T. Novel ready-to-use dry powder formulation of Talaromyces tratensis KUFA0091 to control dirty panicle disease in rice. Biol. Control 2021, 152, 104454. [Google Scholar] [CrossRef]
- Suasa-ard, S.; Eakjamnong, W.; Dethoup, T. A novel biological control agent against postharvest mango disease caused by Lasiodioplodia theobromae. Eur. J. Plant Pathol. 2019, 155, 583–592. [Google Scholar] [CrossRef]
- Al-Hawash, A.B.; Al-Qurnawi, W.S.; Abbood, H.A.; Hillo, N.A.; Ghalib, H.B.; Zhang, X. Pyrene-degrading fungus Ceriporia lacerata RF-7 from contaminated soil in Iraq. Polycycl. Aromat. Compd. 2022, 42, 40–48. [Google Scholar] [CrossRef]
- Yu, Z.; Lang, G.; Kajahn, I.; Schmaljohann, R.; Imhoff, J.F. Scopularides A and B, cyclodepsipeptides from a marine sponge-derived fungus, Scopulariopsis brevicaulis. J. Nat. Prod. 2008, 71, 1052–1054. [Google Scholar] [CrossRef]
- Anbu, P.; Gopinath, S.C.; Hilda, A.; Lakshmipriya, T.; Annadurai, G. Optimization of extracellular keratinase production by poultry farm isolate Scopulariopsis brevicaulis. Bioresour. Technol. 2007, 98, 1298–1303. [Google Scholar] [CrossRef]
- Santi, L.; Beys-da-Silva, W.O.; Berger, M.; Yates, J.R.; Brandelli, A.; Vainstein, M.H. Penicillium oxalicum secretomic analysis identify plant cell wall degrading enzymes important for fruit juice extraction. J. Food Sci. Technol. 2021, 58, 1764–1775. [Google Scholar] [CrossRef]
- Zhang, J.; Liu, S.; Sun, H.; Jiang, Z.; Zhou, Z.; Han, X.; Zhou, Y.; Sun, H.; Zhou, W.; Mao, J. Enzyme production potential of Penicillium oxalicum M1816 and Its application in ferulic acid production. Foods 2021, 10, 2577. [Google Scholar] [CrossRef]
- Kaur, R.; Kaur, J.; Kaur, M.; Kalotra, V.; Chadha, P.; Kaur, A.; Kaur, A. An endophytic Penicillium oxalicum isolated from Citrus limon possesses antioxidant and genoprotective potential. J. Appl. Microbiol. 2020, 128, 1400–1413. [Google Scholar] [CrossRef] [PubMed]
- Wang, J.; Zhao, Y.G.; Maqbool, F. Capability of Penicillium oxalicum y2 to release phosphate from different insoluble phosphorus sources and soil. Folia Microbiol. 2021, 66, 69–77. [Google Scholar] [CrossRef] [PubMed]
- Li, H.; Jiang, J.; Liu, Z.; Lin, S.; Xia, G.; Xia, X.; Ding, B.; He, L.; Lu, Y.; She, Z. Peniphenones A-D from the mangrove fungus Penicillium dipodomyicola HN4-3A as inhibitors of Mycobacterium tuberculosis phosphatase MptpB. J. Nat. Prod. 2014, 77, 800–806. [Google Scholar] [CrossRef]
- Wu, L.; Yin, Z.; Fu, Y.; Yin, C. Biotransformation of major ginsenosides into compound K by a new Penicillium dipodomyicola strain isolated from the soil of wild ginseng. Afr. J. Biotechnol. 2012, 11, 15905–15915. [Google Scholar]
- Gaudin, K.; Ferey, L. Quality by Design: A tool for separation method development in pharmaceutical laboratories. LCGC Suppl. 2016, 29, 16–25. [Google Scholar]
- Abdelrahman, M.M.; Naguib, I.A.; Elsayed, M.A.; Zaazaa, H.A. Chromatographic Methods for Quantitative determination of ampicillin, dicloxacillin and their impurity 6-aminopenicillanic acid. J. Chromatogr. Sci. 2018, 56, 209–215. [Google Scholar] [CrossRef]
- Singh, V.; Haque, S.; Niwas, R.; Srivastava, A.; Pasupuleti, M.; Tripathi, C.K. Strategies for fermentation medium optimization: An in-depth review. Front. Microbiol. 2017, 7, 2087. [Google Scholar] [CrossRef]
- Nijland, J.G.; Ebbendorf, B.; Woszczynska, M.; Boer, R.; Bovenberg, R.A.; Driessen, A.J. Nonlinear biosynthetic gene cluster dose effect on penicillin production by Penicillium chrysogenum. Appl. Environ. Microbiol. 2010, 76, 7109–7115. [Google Scholar] [CrossRef]
- El-Marsafy, M.; Abdel-Akher, M.; El-Saied, H. Effect of media composition on the penicillin production. Zent. Bakteriol Parasitenkd Infekt. Hyg. 1977, 132, 117–122. [Google Scholar] [CrossRef]
- Cook, R.P.; Tulloch, W.J. The production of penicillin using fractions obtained from aqueous extracts of pea (Pisum sativum). Biochem. J. 1945, 39, 314–317. [Google Scholar] [CrossRef]
- Cook, R.P.; Brown, M.B. Effect of the source of nitrogen in the medium on the formation of penicillin by surface cultures of Penicillium notatum. Nature 1947, 159, 376. [Google Scholar] [CrossRef] [PubMed]
- Moyer, A.J.; Coghill, R.D. Penicillin: X. The effect of phenylacetic acid on penicillin production. J. Bacteriol. 1947, 53, 329–341. [Google Scholar] [CrossRef] [PubMed]
- Nagamune, T.; Endo, I.; Kato, N.; Nishimura, M.; Kobayashi, T. The effect of cultivation conditions on the penicillin production using a urethane foam-supported Penicillium chrysogenum. Bioprocess Eng. 1988, 3, 173–176. [Google Scholar] [CrossRef]
- Kumar, V.V.; Vigneshwaran, K.V.; Vasantharaj, J.; Isaac, P.; Bharathiraja, B. Optimization of sugarcane bagasse, nutrient and temperature on the yield of penicillin V in solid state fermentation by Penicillium chrysogenum. Int. J. Biotechnol. Biochem. 2010, 6, 477–483. [Google Scholar]
- Calam, C.T.; Driver, N.; Bowers, R.H. Studies in the production of penicillin, respiration and growth of Penicillium chrysogenum in submerged culture in relation to agitation and oxygen transfer. J. Appl. Chem. 1951, 1, 209–216. [Google Scholar] [CrossRef]
- Owen, S.P.; Johnson, M.J. The effect of temperature changes on the production of penicillin by Penicillium chrysogenum W49-133. Appl. Microbiol. 1955, 3, 375–379. [Google Scholar] [CrossRef] [PubMed]
- Asnaashari, M.; Ghanbary, M.A.T.; Tazick, Z. Optimization of penicillin G production by Penicillium chrysogenum. Ann. Biol. Res. 2013, 3, 5434–5440. [Google Scholar]

| Isolate Name | Molecular Identification | PenV (mg/L) | |
|---|---|---|---|
| ITS | β-tubulin | ||
| BIONCL P1 | P. chrysogenum | P. chrysogenum | 48 |
| BIONCL P2 | P. chrysogenum | P. chrysogenum | ND |
| BIONCL P3 | P. chrysogenum | P. chrysogenum | ND |
| BIONCL P4 | P. chrysogenum | P. chrysogenum | 42 |
| BIONCL P5 | P. chrysogenum | P. chrysogenum | ND |
| BIONCL P6 | P. chrysogenum | P. chrysogenum | 18 |
| BIONCL P7 | P. chrysogenum | P. chrysogenum | 16 |
| BIONCL P8 | P. chrysogenum | P. chrysogenum | 24 |
| BIONCL P9 | P. chrysogenum | P. chrysogenum | ND |
| BIONCL P10 | P. chrysogenum | P. chrysogenum | ND |
| BIONCL P11 | P. chrysogenum | P. chrysogenum | ND |
| BIONCL P12 | P. chrysogenum | P. chrysogenum | ND |
| BIONCL P13 | P. chrysogenum | P. chrysogenum | ND |
| BIONCL P14 | P. chrysogenum | P. chrysogenum | 18 |
| BIONCL P15 | P. chrysogenum | P. chrysogenum | ND |
| BIONCL P16 | P. chrysogenum | P. chrysogenum | ND |
| BIONCL P17 | P. chrysogenum | P. chrysogenum | 3 |
| BIONCL P18 | P. chrysogenum | P. chrysogenum | 63 |
| BIONCL P19 | P. chrysogenum | P. chrysogenum | ND |
| BIONCL P20 | P. chrysogenum | P. chrysogenum | ND |
| BIONCL P21 | P. chrysogenum | P. chrysogenum | ND |
| BIONCL P22 | P. chrysogenum | P. chrysogenum | ND |
| BIONCL P23 | P. chrysogenum | P. chrysogenum | 21 |
| BIONCL P24 | P. chrysogenum | P. chrysogenum | ND |
| BIONCL P25 | P. chrysogenum | P. chrysogenum | ND |
| BIONCL P26 | P. chrysogenum | P. chrysogenum | ND |
| BIONCL P27 | P. chrysogenum | P. chrysogenum | ND |
| BIONCL P28 | P. chrysogenum | P. chrysogenum | ND |
| BIONCL P29 | P. chrysogenum | P. chrysogenum | ND |
| BIONCL P30 | P. chrysogenum | P. chrysogenum | 32 |
| BIONCL P31 | P. chrysogenum | P. chrysogenum | 22 |
| BIONCL P32 | P. chrysogenum | P. chrysogenum | ND |
| BIONCL P33 | P. chrysogenum | P. chrysogenum | 12 |
| BIONCL P34 | P. chrysogenum | P. chrysogenum | ND |
| BIONCL P35 | P. chrysogenum | P. chrysogenum | 24 |
| BIONCL P36 | P. chrysogenum | P. chrysogenum | ND |
| BIONCL P37 | P. chrysogenum | P. chrysogenum | 14 |
| BIONCL P38 | P. chrysogenum | P. chrysogenum | 16 |
| BIONCL P39 | P. chrysogenum | P. chrysogenum | ND |
| BIONCL P40 | P. rubens | P. rubens | 43 |
| BIONCL P41 | P. oxalicum | P. rubens | 21 |
| BIONCL P42 | P. rubens | P. rubens | 24 |
| BIONCL P43 | P. rubens | P. rubens | 14 |
| BIONCL P44 | P. rubens | P. rubens | ND |
| BIONCL P45 | P. rubens | P. rubens | 100 |
| BIONCL P46 | P. rubens | P. rubens | ND |
| BIONCL P47 | P. rubens | P. rubens | ND |
| BIONCL P48 | P. rubens | P. rubens | ND |
| BIONCL P49 | P. rubens | P. rubens | 11 |
| BIONCL P50 | P. rubens | P. rubens | ND |
| BIONCL P51 | P. rubens | P. rubens | ND |
| BIONCL P52 | P. rubens | P. rubens | 16 |
| BIONCL P53 | P. rubens | P. rubens | ND |
| BIONCL P54 | P. rubens | P. rubens | ND |
| BIONCL P55 | P. rubens | P. rubens | ND |
| BIONCL P56 | P. rubens | P. rubens | ND |
| BIONCL P57 | P. rubens | P. rubens | ND |
| BIONCL P58 | P. rubens | P. rubens | ND |
| BIONCL P59 | P. rubens | P. rubens | ND |
| BIONCL P60 | P. rubens | P. rubens | 6 |
| BIONCL P61 | P. rubens | P. rubens | 18 |
| BIONCL P62 | P. rubens | P. rubens | 8 |
| BIONCL P63 | P. rubens | P. rubens | ND |
| BIONCL P64 | P. rubens | P. rubens | ND |
| BIONCL P65 | P. rubens | P. rubens | 18 |
| BIONCL P66 | P. rubens | P. rubens | ND |
| BIONCL P67 | P. rubens | P. rubens | ND |
| BIONCL P68 | P. rubens | P. rubens | 17 |
| BIONCL P69 | P. chrysogenum | P. rubens | ND |
| BIONCL P70 | P. dipodomyicola | P. chrysogenum | ND |
| BIONCL P71 | P. dipodomyicola | P. rubens | ND |
| BIONCL P72 | P. oxalicum | P. rubens | ND |
| BIONCL P73 | P. oxalicum | P. rubens | ND |
| BIONCL P74 | P. oxalicum | P. rubens | ND |
| BIONCL P75 | P. rubens | P. rubens | ND |
| BIONCL P76 | P. rubens | P. rubens | ND |
| BIONCL P77 | P. rubens | P. rubens | ND |
| BIONCL P78 | P. rubens | P. rubens | ND |
| BIONCL P79 | P. rubens | P. rubens | 10 |
| BIONCL P80 | P. rubens | P. rubens | ND |
| BIONCL P81 | P. brocae | P. brocae | NA |
| BIONCL P82 | P. brocae | P. brocae | NA |
| BIONCL P83 | P. brocae | P. brocae | NA |
| BIONCL P84 | P. citrinum | P. citrinum | NA |
| BIONCL P85 | P. citrinum | P. citrinum | NA |
| BIONCL P86 | P. citrinum | P. citrinum | NA |
| BIONCL P87 | P. citrinum | P. citrinum | NA |
| BIONCL P88 | P. citrinum | P. citrinum | NA |
| BIONCL P89 | P. citrinum | P. citrinum | NA |
| BIONCL P90 | P. citrinum | P. citrinum | NA |
| BIONCL P91 | P. citrinum | P. citrinum | NA |
| BIONCL P92 | P. citrinum | P. citrinum | NA |
| BIONCL P93 | P. citrinum | P. citrinum | NA |
| BIONCL P94 | P. citrinum | P. citrinum | NA |
| BIONCL P95 | A. Sydowii | A. sydowii | NA |
| BIONCL P96 | A. Sydowii | A. sydowii | NA |
| BIONCL P97 | A. Sydowii | A. sydowii | NA |
| BIONCL P98 | A. Sydowii | A. sydowii | NA |
| BIONCL P99 | A. Sydowii | A. sydowii | NA |
| BIONCL P100 | A. Sydowii | A. sydowii | NA |
| BIONCL P101 | A. Sydowii | A. sydowii | NA |
| BIONCL P102 | A. Sydowii | A. sydowii | NA |
| BIONCL P103 | A. Sydowii | A. sydowii | NA |
| BIONCL P104 | A. Sydowii | A. sydowii | NA |
| BIONCL P105 | A. Sydowii | A. sydowii | NA |
| BIONCL P106 | A. Sydowii | A. sydowii | NA |
| BIONCL P107 | A. fumigatus | A. fumigatus | NA |
| BIONCL P108 | S. brevicaulis | S. brevicaulis | NA |
| BIONCL P109 | T. tratensis | T. tratensis | NA |
| Parameter | Pen V | 6-APA | POA |
|---|---|---|---|
| Range | 100–500 µg/mL | 100–500 µg/mL | 100–500 µg/mL |
| Slope | 39,169 | 22,730 | 27,287 |
| Intercept | 925,634 | 190,701 | 400,000 |
| R2 | 0.9988 | 0.9999 | 0.9373 |
| LOD | 5 µg/mL | 10 µg/mL | 7 µg/mL |
| LOQ | 10 µg/mL | 10 µg/mL | 10 µg/mL |
| Species | Enzyme/Metabolite | Application | References |
|---|---|---|---|
| P. chrysogenum | Roquefortine C; Chrysogine; Sorbicillin; Meleagrin; Andrastin A; Xanthocillin X; Secalonic acid D; Lumpidin; Penicillin | Antimicrobial Cheese making | Present study |
| P. rubens | Chrysogine; Sorbicillin; Andrastin A; Xanthocillin X; Lumpidin; Penicillin | Antimicrobial | Present study |
| P. brocae | Fumigatin chlorohydrin; iso-fumigatin chlorohydrin; Penicibrocazine A–E; Brocazines A−G; Spirobrocazine C; Ergosterol; Brocaenol A–C | Antimicrobial, Cytotoxic, Symbiotically associated with insect and provide nutrient | [38,39,40,41,42,43] |
| P. citrinum | Epiremisporine B, D, E; Penicitrinone A; β-glucosidases; Epiremisporine F-H; polyketides and steroids; Cyclopeniol; Gibberellins; Fungal conidia | Anti-inflammatory and cytotoxic; Biomass saccharification; Antifungal; Antiviral; Mosquito controller; Plant growth promoter | [44,45,46,47,48,49,50] |
| A. Fumigatus | β-xylosidase; Cellulase; Amylase; Pectinase; Phosphatase and phytase | Bioethanol production; Textile, detergent, food and feed industries. | [51,52,53,54,55] |
| A. sydowii | Keratinase; Sydowione A–B; Acremolin D; Acremolin C; Lignin and Manganese peroxidase | Degradation of keratinous materials; Antioxidant; Antiproliferative; Antibacterial | [56,57,58,59] |
| T. tratensis | Dry powder formulation; Cell free supernatant | Antagonistic activity against plant diseases and growth promotor | [60,61] |
| S. brevicaulis | Scopularides A–B; Keratinase | Bioremediation of PAH; Degradation of keratinous material; Anticancer and antibacterial activity | [62,63,64] |
| P. oxalicum | Polygalacturonase, pectin lyase, pectinesterase; Cellulase, xylanase and feruloyl esterase; Polyphenolic compounds; Organic acids | Clarification and Depectinization of juice; Ferulic acid production; Antioxidant and genoprotective activity. Biofertilizer | [65,66,67,68] |
| P. dipodomyicola | Peniphenone B–C; β-glucosidase | Antibacterial activity; Biotransformation of ginsenoside | [69,70] |
Disclaimer/Publisher’s Note: The statements, opinions and data contained in all publications are solely those of the individual author(s) and contributor(s) and not of MDPI and/or the editor(s). MDPI and/or the editor(s) disclaim responsibility for any injury to people or property resulting from any ideas, methods, instructions or products referred to in the content. |
© 2023 by the authors. Licensee MDPI, Basel, Switzerland. This article is an open access article distributed under the terms and conditions of the Creative Commons Attribution (CC BY) license (https://creativecommons.org/licenses/by/4.0/).
Share and Cite
Sawant, A.M.; Navale, V.D.; Vamkudoth, K.R. Isolation and Molecular Characterization of Indigenous Penicillium chrysogenum/rubens Strain Portfolio for Penicillin V Production. Microorganisms 2023, 11, 1132. https://doi.org/10.3390/microorganisms11051132
Sawant AM, Navale VD, Vamkudoth KR. Isolation and Molecular Characterization of Indigenous Penicillium chrysogenum/rubens Strain Portfolio for Penicillin V Production. Microorganisms. 2023; 11(5):1132. https://doi.org/10.3390/microorganisms11051132
Chicago/Turabian StyleSawant, Amol M., Vishwambar D. Navale, and Koteswara Rao Vamkudoth. 2023. "Isolation and Molecular Characterization of Indigenous Penicillium chrysogenum/rubens Strain Portfolio for Penicillin V Production" Microorganisms 11, no. 5: 1132. https://doi.org/10.3390/microorganisms11051132
APA StyleSawant, A. M., Navale, V. D., & Vamkudoth, K. R. (2023). Isolation and Molecular Characterization of Indigenous Penicillium chrysogenum/rubens Strain Portfolio for Penicillin V Production. Microorganisms, 11(5), 1132. https://doi.org/10.3390/microorganisms11051132

